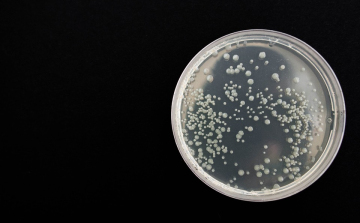
A felmelegedéssel több baktériumfertőzés várható

Hírek

2022. Április 21. 16:05, csütörtök | Életmód
A prosztatarákhoz köthető baktériumokat azonosítottak
A prosztatarák agresszív formájához köthető baktériumokat fedeztek fel angol kutatók, akik azt remélik, eredményeik forradalmasíthatják a betegség legsúlyosabb változatának megelőzését és gyógyítását.

2021. Július 03. 15:08, szombat | Életmód
A szarvasmarhák gyomrában élő baktériumok képesek lebontani a műanyagokat
A szarvasmarhák gyomrában élő baktériumok képesek a műanyagok lebontására is - ezt állapította meg egy most publikált kutatás.

2020. Október 30. 08:33, péntek | Belföld
Baktériummal szennyezett sonkát von ki a forgalomból egy áruházlánc
Az Aldi Magyarország Élelmiszer Bt. és a Principe di San Daniele Spa visszahívja a Hola Serrano sonkát, mert annak egy mintájában Listeria baktériumot mutattak ki - közölte az áruházlánc az MTI-vel pénteken.

2020. Szeptember 16. 05:00, szerda | Belföld
Baktérium miatt visszahívtak egy húskészítményt a forgalomból
Visszahívta a forgalomból a Nemzeti Élelmiszerlánc-biztonsági Hivatal (Nébih) a Bio Münchner Weißwurst megnevezésű fehér kolbászt - olvasható a Nébih honlapján közzétett felhívásban.
2020. Június 18. 17:02, csütörtök | Életmód
A felmelegedéssel több baktériumfertőzés várható
A globális felmelegedéssel több olyan fertőzéses megbetegedés várható, melyet a vibrió elnevezésű, pálca alakú baktériumok okoznak – állapította meg egy német kutatócsoport.

2019. Szeptember 16. 18:01, hétfő | Életmód
Néhány év alatt ellenállóvá válhat egy baktérium
Akár néhány év alatt ellenállóvá válhat egy baktérium egy adott antibiotikummal szemben

2019. Július 05. 07:46, péntek | Külföld
Húsevő baktériumok fertőznek az Egyesült Államokban
Húsevő baktériumoktól származó fertőzés bukkant fel az Egyesült Államok keleti partvidékén, az amerikai médiumok a napokban több ilyen esetről beszámoltak.

2018. December 07. 08:48, péntek | Életmód
A baktériumok fertőzőképességét meggátoló szénhidrátokat állítottak elő debreceni kutatók
A Debreceni Egyetem szénhidrátkémiai kutatócsoportja olyan vegyületeket állított elő, amelyek megakadályozhatják baktérium által okozott fertőzés kialakulását.

2018. Szeptember 24. 16:01, hétfő | Belföld
Baktérium okozta a tömeges megbetegedéseket Domoszlón és Kisnánán
Az első vizsgálati eredmények alapján Campylobacter nevű baktérium okozta a hányással, hasmenéssel, magas lázzal járó tömeges megbetegedéseket Domoszlón és Kisnánán

2018. Augusztus 29. 13:09, szerda | Belföld
A klímaváltozás miatt elfelejtett kórokozók jelenhetnek meg újra
A jégtáblák olvadásával olyan régi kórokozók kerülnek elő, mint a pestis vagy a lépfene - mondta Rusvai Miklós virológus az M1 aktuális csatorna szerdai műsorában.

2017. Május 31. 04:58, szerda | Életmód
Ultraerős antibiotikumot hoztak létre a szuperbaktériumok elleni harcban kutatók
Egy régi antibiotikum molekuláris szerkezetének stratégiai módosításaival akarják felvenni a harcot az antibiotikum-rezisztens szuperbaktériumok ellen amerikai tudósok.

2017. Január 27. 08:06, péntek | Belföld
Baktérium miatt betegedtek meg tömegesen a határon szolgáló rendőrök
Baktérium okozta a déli határon történt tömeges rendőri rosszulléteket január elején a laborvizsgálatok szerint - írja a Magyar Nemzet pénteki számában.

2016. Május 28. 05:00, szombat | Külföld
A legerősebb antibiotikumnak is ellenálló fertőzéses esetet találtak Amerikában
Először fordult elő az Egyesült Államokban olyan baktériumfertőzéses esetet, amely a legerősebb antibiotikummal szemben is ellenálló volt. A tudósok úgy vélik, aggasztó, hogy kimerült az antibiotikumok tárháza.
